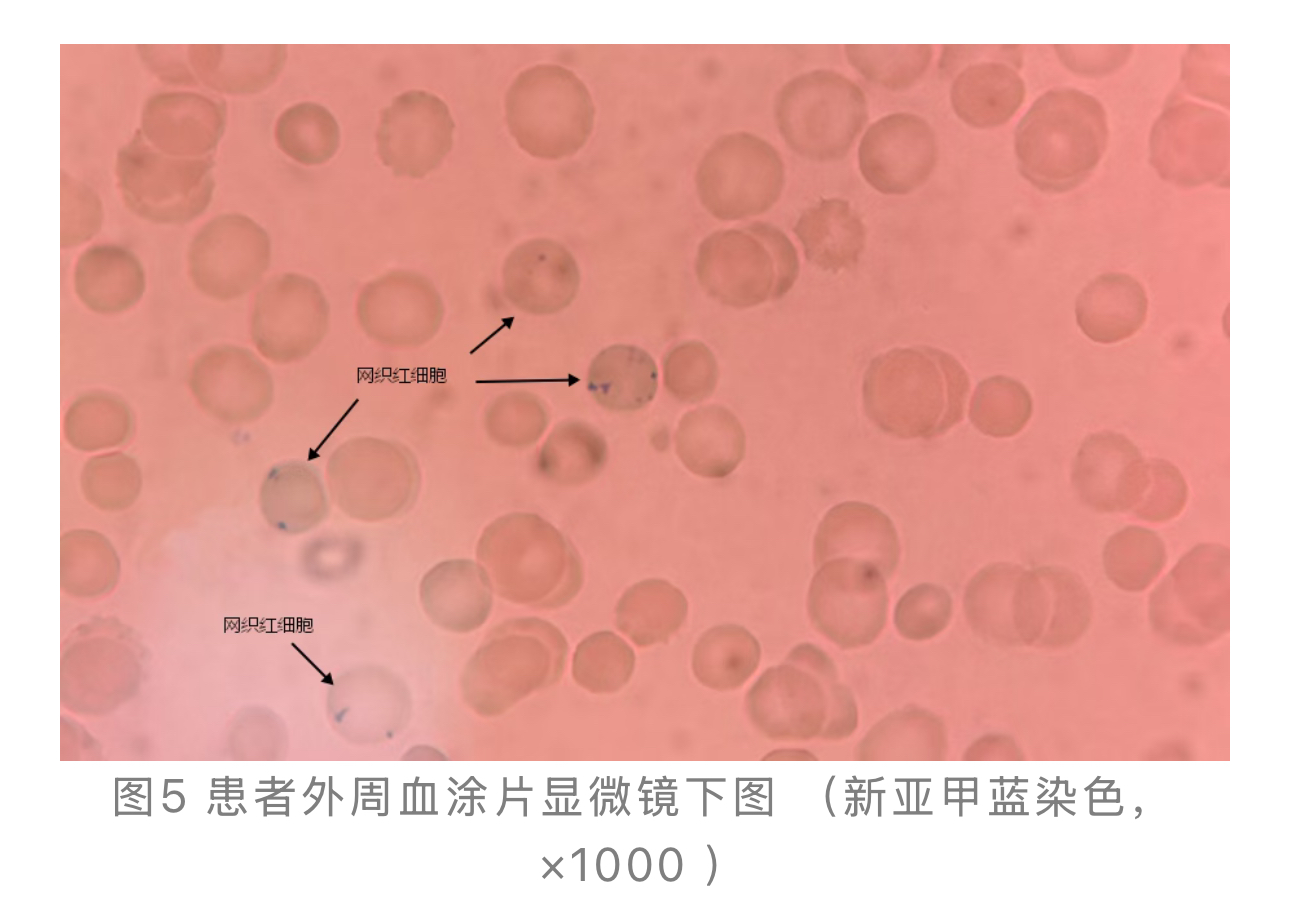
1774245494537046.jpg 1774245494537046.jpg

颅内出血背后的“隐秘杀手”——一例多系统受累病例如何锁定罕见Evans综合征
作者:田一娟,东莞市高埗医院检验科
前言
Evans综合征(ES)是一种罕见的自身免疫性疾病,其特征是同时或相继发生至少两种自身免疫性血细胞减少,最常见为自身免疫性溶血性贫血
(AIHA)和免疫性血小板减少症
(ITP)[1]。
其临床表现具有高度异质性,诊断需在确立AIHA与ITP并存的基础上,积极排除其他原因所致的类似血象改变。当ES以颅内出血
(ICH)等危及生命的并发症为首发或突出表现时,快速而审慎的诊断评估尤为关键。
本文通过一例以ICH起病的复杂病例,展现如何依托检验医学的关键发现,在多学科协作框架下,将诊断思路高度聚焦于ES,并明确后续验证与鉴别路径的临床思维过程。
案例经过
临床病史与初步检查:
患者,女性,47岁,因“头痛
、头晕3月余”就诊。CT提示右侧额叶脑出血
收入神经外科。患者自诉2025年07月上旬无明显诱因下出现头痛、头晕,以右额部为主,无意识丧失,无恶心、呕吐
,无四肢抽搐,无发热
等不适,发病前曾有头部外伤史,右枕部不慎有一次撞击硬金属情况,当时无意识丧失,无头部出血,未予特殊处理。月经量增多。既往有血压升高史、甲亢病史。
入院查体:血压143/85 mmHg,全身皮肤、巩膜黄染,左下肢内侧可见瘀斑,大小约3*2cm。神经系统查体除与出血定位相关表现外,GCS评分15分。
关键初步检验结果:
1.血常规
:白细胞计数(WBc)4.29×109/L,血红蛋白(Hb)81 g/L,血小板(PLT)22.2×109/L,呈中度贫血伴血小板重度减少(见图1)。

2.生化:血糖检查(GLI)6.68mmol/L,总胆红素78.40 umol/L,以间接胆红素
升高为主(62.80 umol/L)。胆红素升高模式提示溶血可能(见图2)。

3. 影像学:行 MRI 检查,MRI示右侧额叶血肿(见图3);超声示脾大
(142mm*42mm)、脂肪肝
、子宫肌瘤
、左附件区混合回声。

通过病历信息与各项检查结果,归纳出患者存在多重异常情况 :①颅内出血性病灶;②严重血小板减少伴贫血;③溶血性黄疸
与脾大;④妇科占位性病变;⑤肿瘤标志物
CA153轻度升高。
病情涉及神经、血液、消化、妇科等多个系统,诊断方向包括但不限于:血液系统恶性肿瘤(如白血病
、淋巴瘤
)、血栓性微血管病(TTP)、继发于妇科肿瘤
的副肿瘤综合征、自身免疫性疾病(如系统性红斑狼疮
)等。为此,启动了多学科病例讨论。在多学科框架下,检验科针对血液系统异常进行了定向深挖,补充了以下检查:
1.外周血细胞形态学检查:镜下可见血小板数量显著减少,红细胞大小不一,可见嗜多色性红细胞、嗜碱性点彩红细胞
。(见图4)。

2.网织红细胞计数:结果为0.051(5.1%),明显高于参考值(见图5)。
3. 直接抗人球蛋白试验
(DAT,Coombs试验)结果为阳性。
基于AIHA证据链(贫血、间接胆红素升高、网织红细胞增高、DAT阳性) 与严重的血小板减少,综合考虑Evans综合征[2]。
4.骨髓形态检查:因患者转院未完成该项检查,结果缺失。
案例分析
1. 检验诊断路径的核心价值:本例诊断的关键在于检验指标的递进式分析与整合。初始的全血细胞减少和黄疸仅为非异性警报。通过血细胞形态学发现嗜多色性红细胞和嗜碱性点彩红细胞,网织红细胞升高,证实了溶血的存在。
DAT阳性将溶血指向自身免疫性机制上,从而构建了AIHA诊断依据。DAT阳性是连接溶血与血小板减少,指向ES这一综合诊断的核心桥梁[2]。因骨髓形态检查缺失,本案例未将骨髓检查结果纳入诊断依据,仅依托外周血相关指标完成 AIHA 及 ES 的初步诊断。
2. 与关键疾病的鉴别诊断:本例的鉴别诊断重点在于排除其他导致贫血和血小板减少的疾病。
血栓性血小板减少性紫癜
(TTP):同样表现为血小板减少和微血管病性溶血。但典型TTP患者DAT通常为阴性,且常伴有更严重的神经精神症状、发热及肾功能损害[2,3]。本例DAT阳性,且神经系统症状可用颅内出血灶解释,不支持TTP。
骨髓增生异常综合征
(MDS):可表现为全血细胞减少,但外周血或骨髓常可见特征性的病态造血现象,且DAT阴性。因患者转院未完成骨髓形态检查,无骨髓相关结果参考,但本例DAT阳性,且骨髓代偿性增生表现(如晚幼红细胞、网织红细胞增高)更符合溶血性贫血,而非MDS的无效造血。
阵发性睡眠性血红蛋白尿症
(PNH):为获得性血管内溶血,DAT阴性,流式细胞术可检测到CD55、CD59缺失。本例DAT阳性,可基本排除典型PNH。
3. 颅内出血的病因学思考:患者血小板计数极低(22.2×10⁹/L),是发生自发性颅内出血的极高危因素。有报导指出,ES可引起严重的出血并发症[3]。因此,高度怀疑本次颅内出血的主要原因是ES并发的ITP。虽曾有头部外伤史,但严重的血小板减少极大可能放大了外伤的后果或诱发了自发性出血。
4. “继发性”ES的思考与后续方向:确诊ES并非终点。患者为女性,合并甲亢病史(自身免疫性甲状腺疾病
)及妇科占位,提示本病可能为继发性ES。有文献报导,ES可继发于自身免疫性疾病、淋巴增殖性疾病或实体瘤、Graves 病等[2-4]。
因此,须后续完善自身抗体谱(ANA、抗dsDNA等)、抗磷脂抗体
、全身影像学评估及妇科占位的病理学检查,同时建议后续完善骨髓形态检查以进一步佐证诊断、排除血液系统其他疾病,以明确潜在的继发疾病,指导整体治疗。
总结
本例是一例以危重神经系统并发症为首发表现的多系统疾病。通过系统性的探查——从血细胞形态提示代偿造血,到网织红细胞定量证实溶血,最终通过DAT阳性锁定自身免疫性溶血——因患者转院未完成骨髓形态检查,本次诊断未纳入骨髓相关结果,仅依托外周血系列检验指标,成功将复杂的临床表象整合,高度聚焦于Evans综合征这一诊断。
本案例提示:
1. 对于全血细胞减少伴黄疸的患者,应遵循“全血细胞计数
→血细胞形态→网织红细胞计数→DAT”的阶梯式检验诊断路径。
2. DAT是鉴别免疫性与非免疫性溶血的核心,其阳性结果对提示ES具有关键价值。
3. 对疑似ES的病例,须进行系统性的继发因素筛查。
4. 多学科协作是处理此类复杂、危重病例,实现快速诊断与有效治疗的基石。
专业审核:周卫平
(南通市通州区人民医院)
参考文献
[1] Evans RS, Takahashi K, Duane RT, et al. Primary thrombocyto-penic purpura and acquired hemolytic anemia; evidence for a common etiology[J]. AMA Arch Intern Med, 1951, 87(1):48-65. DOI: 10.1001/archinte.1951.03810010058005.
[2] 中华医学会血液学分会红细胞疾病(贫血)学组. Evans综合征诊断和治疗中国专家共识(2024年版)[J]. 中华血液学杂志, 2024, 45(9): 810815.
[3] 徐世荣, 郭晓
楠, 张静
楠. Evans综合征的研究现状[J]. 诊断学理论与实践, 2010, 9(3):218–221.
[4] 金亚,廖二元.Graves 病合并 Evans 综合征一例[J].中华内科杂志,2002,41(10):659.
来源:数智检验医学